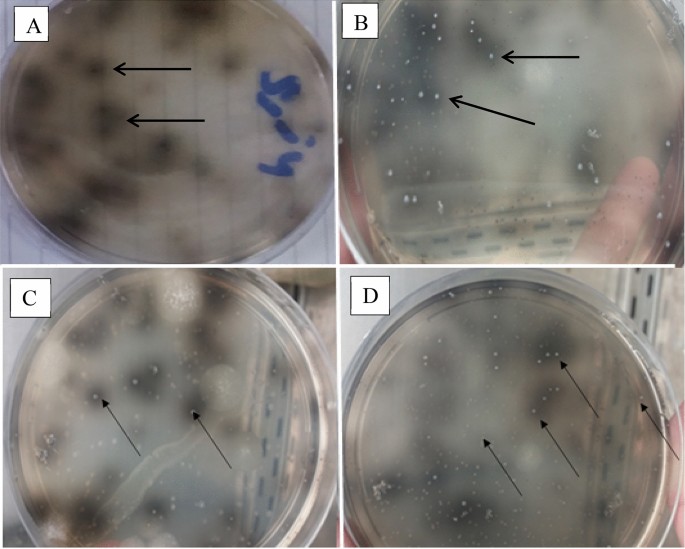

2 Ways Bacteria Cause Disease
2 ways bacteria cause disease. Other bacteria like Neisseria gonorrhea and Chlamydia trachomatis spread via sexual contacts. Bacteria produce disease in one of two general ways. An infectious agent is simply an organism that is capable of getting past your defenses and then livinggrowing inside or you.
Despite the important structural and cultural differences both bacteria and viruses can cause disease in similar ways. Inside the body these bacteria reproduce quickly. For example antibiotic treatment and surgery cause pseudomembranous colitis due to toxin production by Clostridium difficile and sepsis of Escherichia coli Enterococcus faecalis and Enterococcus faecium and intra-abdominal abscesses due to Bacteroides fragilis 51.
Bacteria cause illnesses such as strep throat and food poisoning. It is often found in unhygienic kitchens undercooked foods such as meat. Disease occurs when the cells in your body are damaged as a result of infection and signs and symptoms of an illness appear.
Bacteria and viruses are microbes germs which are very different to each other in structure and function. The process of infecting the host is called invasiveness. Bacterial meningitis is an.
Bacterial infections are treated with drugs called antibiotics such as penicillin. Even the virulence factors they produce to help them invade the body often do little real harm. Both bacteria and viruses can cause disease.
However these two types of infectious agents achieve their pathogenicity in different ways. Methicillin-resistant Staphylococcus aureus MRSA are bacteria that can cause serious health issues. The incidence of disease among those infected varies greatly depending on the particular pathogen and individual susceptibility.
Some bacteria cause diseases including food poisoning meningitis and scarlet fever. This often means abdominal cramps vomiting and diarrhoea.
Sometimes bacteria are transmitted directly or indirectly from animals to humans and cause disease.
Bacterial meningitis is an. 7 Scary Diseases Caused by Bacteria 01. They produce poisons that make you feel ill. An infectious agent is simply an organism that is capable of getting past your defenses and then livinggrowing inside or you. Such infections are called zoonotic infections. Sometimes bacteria are transmitted directly or indirectly from animals to humans and cause disease. Bacterial meningitis is an. Virulence factors are normally enzymes. Bacteria cause illnesses such as strep throat and food poisoning.
The process of infecting the host is called invasiveness. Some bacteria cause diseases including food poisoning meningitis and scarlet fever. Methicillin-resistant Staphylococcus aureus MRSA are bacteria that can cause serious health issues. An infectious agent is simply an organism that is capable of getting past your defenses and then livinggrowing inside or you. The two ways that bacteria cause disease are via infection and creating toxins. How Bacteria cause Disease in Living Organisms Cell Damage by Intracellular Bacteria. Sometimes bacteria are transmitted directly or indirectly from animals to humans and cause disease.







/what-is-a-bacterial-infection-7705652_final-2f1b8b2429b2495c8333b584512d3afa.jpg)

Post a Comment for "2 Ways Bacteria Cause Disease"